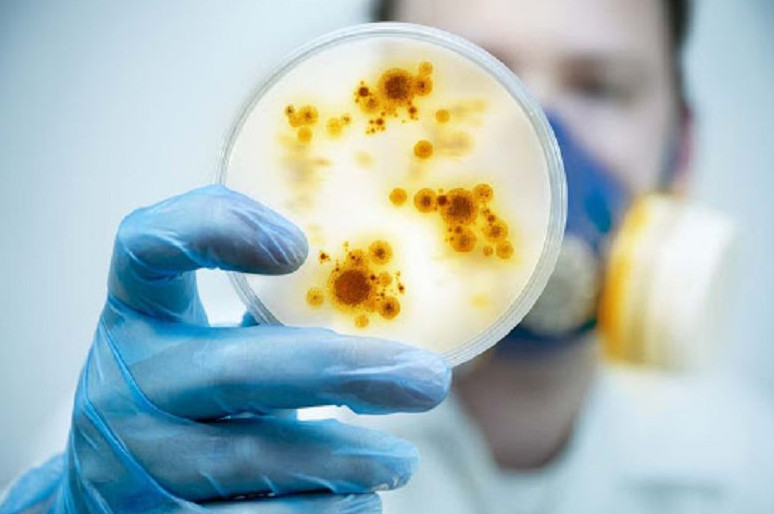
Елімізде жұқпалы ауру едәуір азайды

ауру
Медицина • 18 Қараша, 2025
Алматының медициналық мекемелері неге күшейтілген режимге көшті?
Дәл осы күндері мегаполисте ЖРВИ мен тұмау өршіп тұр. Мұндайда азаматтарға көрсетілетін медициналық көмек қалай ұйымдастырылады деген мәселе күн тәртібіне шығады, деп хабарлайды Egemen.kz.
Медицина • 05 Қараша, 2025
Алматылық дәрігерлер жүрек ауруын емдеудің озық әдісін тапты
Соңғы жылдары дәрігерлерге кальцийленген артериялық атеросклероз диагнозы қойылған науқастар жиі жүгіне бастаған. Мұндай жағдайда қан тамыры қабырғалары қатайып, икемділігін жоғалтады да, стандартты баллондық ангиопластикамен оларды кеңейту мүмкін емес. Соған байланысты қалалық кардиологиялық орталық кальцийленген артерияны емдеудің озық әдісін енгізді.
Медицина • 23 Қазан, 2025
Алматыда балалардың туабітті жүрек ауруларын анықтау мәселелері талқыланды
Бүгін Алматының Өңірлік коммуникациялар қызметі алаңында жүрек кінәраттарымен (ТЖА) туған балаларды ерте диагностикалау мен қолдау мәселелеріне арналған баспасөз мәслихаты өтіп, оған «Heart Center Foundation» қоғамдық қорының директоры Мұрат Зауыров, University Medical Center клиникалық академиялық педиатрия департаментінің директоры, балалар кардиологы Татьяна Иванова-Разумова, UMC Жүрек орталығының балалар кардиологы Айкерім Жанатқызы қатысып, ата-аналар мен дәрігерлерге арналған ауқымды білім беру бағдарламасы туралы баяндады. Бұл бағдарлама жүректің туа бітті кеселдері жөнінде қоғамның хабардарлығын арттыра отырып, бұл дерттерді асқындырмай диагностикалауды дамытуды көздейді, деп жазады Egemen.kz.
Медицина • 21 Қазан, 2025
Дәрі-дәрмекті тіркеу мерзімі жеделдетілді
Қазақстанда дәрі-дәрмек бағасын қалыптастыру жүйесі қайта қаралып, артық шығындар жойылды. Нәтижесінде балама препараттардың құны түпнұсқа дәрілерге қарағанда 30 пайызға дейін арзандады. Тек ең жоғары шығынды ТОП-20 дәрі түрі бойынша күтілетін үнем көлемі 12 млрд теңгегені құрайды, деп хабарлайды Egemen.kz.
Медицина • 21 Қазан, 2025
Елімізде соңғы үш жылда 633 медициналық нысан бой көтерді
Соңғы үш жылда ел аумағында 633 жаңа денсаулық сақтау нысаны салынды. Олардың қатарында Астанадағы Ұлттық онкологиялық орталық пен Шұғыл медицина орталығы, сондай-ақ Алматы қаласындағы Инфекциялық аурулар орталығы секілді ірі жобалар бар, деп хабарлайды Egemen.kz.
Оқиға • 21 Қазан, 2025
Елімізде сәби өлімі 20,2%-ға төмендеді
Президент Қасым-Жомарт Тоқаевтың «Әділетті Қазақстан: заң мен тәртіп, экономикалық өсім, қоғамдық оптимизм» атты Жолдауында берілген тапсырмалар аясында еліміздің денсаулық сақтау жүйесі кешенді жаңғыртудан өтіп жатыр, деп хабарлайды Egemen.kz Үкіметтің баспасөз қызметіне сілтеме жасап.
Денсаулық • 14 Қазан, 2025
Ерейментауда 7 адам уланып қалды
Ақмола облысының Ерейментау ауданында жаппай улану оқиғасы тіркелді, деп хабарлайды Egemen.kz.
Оқиға • 14 Қазан, 2025
Қызылордада 6,5 келілік алып бала дүниеге келді
Көпбейінді облыстық ауруханада Қармақшы ауданының тұрғыны Салтанат Ұзақбай салмағы 6 келі 500 грамм болатын нәрестені дүниеге әкелді, деп хабарлайды Egemen.kz.
Заң • 13 Қазан, 2025
Астанада психикалық ауытқуы бар 6 тұрғынға жүргізуші куәлігі берілген
Елорда прокуратурасы психикалық ауруы бар деп танылып, қылмыстық жауапкершіліктен босатылған 6 адамның қолданыстағы жүргізуші куәлігі бар екенін анықтады, деп жазады Egemen.kz.
Медицина • 08 Қазан, 2025
Астаналықтар бірнеше медициналық скринингтен тегін өте алады
Созылмалы және қатерлі ауруларды ерте анықтау мақсатында тегін мемлекеттік медициналық көмектің кепілдендірілген көлемі (ТМККК) аясында Астанада тегін скрининг шарасы өтеді, деп жазады Egemen.kz.
Оқиға • 08 Қазан, 2025
Оралда аурухана науқастың өлімі үшін 3 млн-нан астам өтемақы төлейді
Батыс Қазақстан облысында 45 жастағы әйелдің өліміне байланысты сот аурухана қызметкерлерінің кінәсін анықтап, марқұмның анасы мен әпкесінің пайдасына моральдық өтемақы өндіру туралы шешім шығарды, деп хабарлайды Egemen.kz.
Денсаулық • 07 Қазан, 2025
Арқалық қаласының тұрғыны ота үстелінде жан тапсырды
Арқалық ауруханасында 61 жастағы қала тұрғыны Тасболат Сақыпов ота үстінде жан тапсырды, деп жазады Egemen.kz.
Медицина • 25 Қыркүйек, 2025
Елімізде жұқпалы ауру едәуір азайды
Жыл басынан бері елімізде жұқпалы аурулар бойынша эпидемиологиялық жағдай тұрақты болды. Профилактикалық және эпидемияға қарсы іс-шаралардың арқасында оба, тырысқақ, дифтерия, полиомиелит, іш сүзегі және паратифті қоса алғанда, 21 инфекциялық ауру тіркелмеген, деп жазады Egemen.kz.
Оқиға • 23 Қыркүйек, 2025
Зерендіде 85 медицина қызметкерінің еңбек құқығы қорғалды
Ақмола облысы, Зерендi ауданы прокуратурасына аудандық аурухана қызметкерлері жыл сайынғы еңбек демалысына төлемақының берілмеуіне байланысты жүгінді, деп хабарлайды Egemen.kz.
Ғылым • 22 Қыркүйек, 2025
Ғалымдар жүрек ауруының алдын алатын платформа жасады
Отандық зерттеушілер жүрек-қан тамырлары ауруының алдын алуға арналған платформа жасап шығарды. Әл-Фараби атындағы Қазақ ұлттық университетінің ғалымдары әзірлеген «Zhurek AI» платформасы дерттің қауіптілігін ерте анықтауға мүмкіндік береді, деп хабарлайды Egemen.kz.
Медицина • 16 Қыркүйек, 2025
Астанада балаларға қандай күрделі операциялар тегін жасалады
Кейінгі жеті айда елордадағы №2 көпсалалы балалар ауруханасында 500 мың теңгеден асатын ондаған тегін операция жасалған, деп жазады Egemen.kz.
Медицина • 08 Қыркүйек, 2025
Елімізде жаңа 538 медициналық нысан пайдалануға берілді
Мемлекет басшысының тапсырмасына сәйкес елімізде медициналық инфрақұрылымды жетілдіру және заманауи емдеу әдістерін енгізу бағытында «Ауылдық денсаулық сақтауды жаңғырту» ұлттық жобасы жүзеге асырылып жатыр, деп хабарлайды Egemen.kz.
Аймақтар • 04 Қыркүйек, 2025
Ақтауда алғаш рет онкологиялық ауруларды ерте диагностикалау орталығы ашылды
Денсаулық сақтау министрлігінің мәліметінше, позитрондық-эмиссиялық томография орталығы (ПЭТ/КТ) онкологиялық аурулардың қайталануын ерте сатысында анықтауға мүмкіндік береді, деп жазады Egemen.kz.
Реформа • 23 Тамыз, 2025
Медицина ұйымдарын енді полиция күзетеді
Бүгінгі таңда медицина саласының қызметкерлеріне күш қолдану деректері жиілеп кетті. Осы олқылықтың алдын алу үшін Шымкент қаласы денсаулық сақтау басқармасы мен полиция департаменті бірлесіп, емдеу мекемелеріне полиция бекеттерін орналастырды, деп жазады Egemen.kz.
Елорда • 01 Тамыз, 2025
Астанадағы 6 аурухананы полиция күзетеді
Астана қаласының алты стационарында медицина қызметкерлерінің қауіпсіздігін қамтамасыз ету үшін тәулік бойы жұмыс істейтін күзет бекеттері ұйымдастырылды, деп жазады Egemen.kz.
Қоғам • 28 Шілде, 2025
Астанадағы ауруханада жүкті әйел сәбиінен айырылып қалды
Елордадағы ауруханада жүкті әйел сәбиінен айырылып қалды, деп хабарлайды Egemen.kz.
Денсаулық • 19 Шілде, 2025
Киік еті қауіпсіз: барлық кезеңде жіті тексеріледі
Киіктердің санын реттеу жұмыстарын «Охотзоопром» РМК қызметкерлері жүзеге асырады. Киіктің сойылған ұшалары рефрижераторларға салынып, сою пункттеріне жеткізіледі, деп жазады Egemen.kz.
Медицина • 16 Шілде, 2025
Елімізде қызылша, көкжөтелмен сырқаттанушылар азайған
Осы жылдың алғашқы 6 айының қорытындысы бойынша Қазақстандағы эпидемиологиялық жағдай тұрақты. Бұл туралы Денсаулық сақтау министрлігінің Санитариялық-эпидемиологиялық бақылау комитеті мәлімдеді, деп жазады Egemen.kz.
Аймақтар • 11 Шілде, 2025
Маңғыстауда дәрігер мамандар жетіспейді
Маңғыстау облысында 250-ге жуық дәрігер жетіспейді. Бұл туралы облыстық денсаулық сақтау басқармасының басшысы Бекболат Ізбасаров мәлімдеді, деп хабарлайды Egemen.kz.
Медицина • 02 Маусым, 2025
Елімізде «инфаркт жасарып келе ме»
Кейінгі жылдары БАҚ беттері мен қоғамда «Инфаркт жасарып келеді» деген тіркес жиі жарияланып, талқыланып жүр. (1, 2, 3) Бұл медиа-өкілдерінің алдын ала қаққан дабылы ма? Қоғамның осы мәселе төңірегіндегі қорқынышына нақты қандай негіз бар? Фактчекинг негізіндегі бұл материалымызда осы сауалдарға Қазақстандағы үрдіс пен әлемдегі тенденция аясында жауап береміз, деп жазады Egemen.kz.
Медицина • 29 Мамыр, 2025
Бүйрекке арналған препарат өндірісі іске қосылды
Алматыда «Нобел Алматы фармацевтикалық фабрикасы» базасында бүйректің созылмалы ауруы (ХБА), жүрек жеткіліксіздігі және 2-типті қант диабетін емдеуге арналған «Форсига» препаратының жергілікті өндірісі жұмысын бастады. Жоба шетелдік инвестормен бірлесіп жүзеге асырылып жатыр. Бұл туралы Денсаулық сақтау министрлігі хабарлады, деп жазады Egemen.kz.
Оқиға • 22 Мамыр, 2025
Емші ер адамды балғамен ұрып, омыртқасын сындырған
Емшінің емінен кейін аяғы ұйыған 50 жастағы Шымкент тұрғыны сол күні кешкілік ауруханаға шұғыл жеткізілген, деп хабарлайды Egemen.kz.
Құрылыс • 18 Мамыр, 2025
Абай облысында аурухана іргетасы қаланды
Медициналық қызметтердің сапасы мен тиімділігін арттыру, халықтың денсаулығын жақсарту – мемлекеттің басты міндеттерінің бірі екені Мемлекет басшысының әр Жолдауында айтылып келеді. Осы ретте Абай елінің көптен көкейінде жүрген облыстық аурухана салу мәселесін шешілетін болды.
Медицина • 16 Мамыр, 2025
Павлодарда 11 мыңға жуық адам жүрек ауруымен есепте тұр
Дәрігерлер бұл дерттің жылдан жылға «жасарып» бара жатқанын айтады. Бұған ең алдымен, тұрғындардың өз денсаулығына салғырт қарауы себеп, деп хабарлайды Egemen.kz.
Медицина • 13 Мамыр, 2025
Әйелдер ауруының алдын алудың амалдары қандай
Елімізде 12 мамырда денсаулық апталығы басталды. Президент жанындағы Әйелдер істері және отбасылық-демографиялық саясат жөніндегі ұлттық комиссия ұйытқы болған шаралар легі маңызды 4 бағытты қамтиды, деп жазады Egemen.kz.